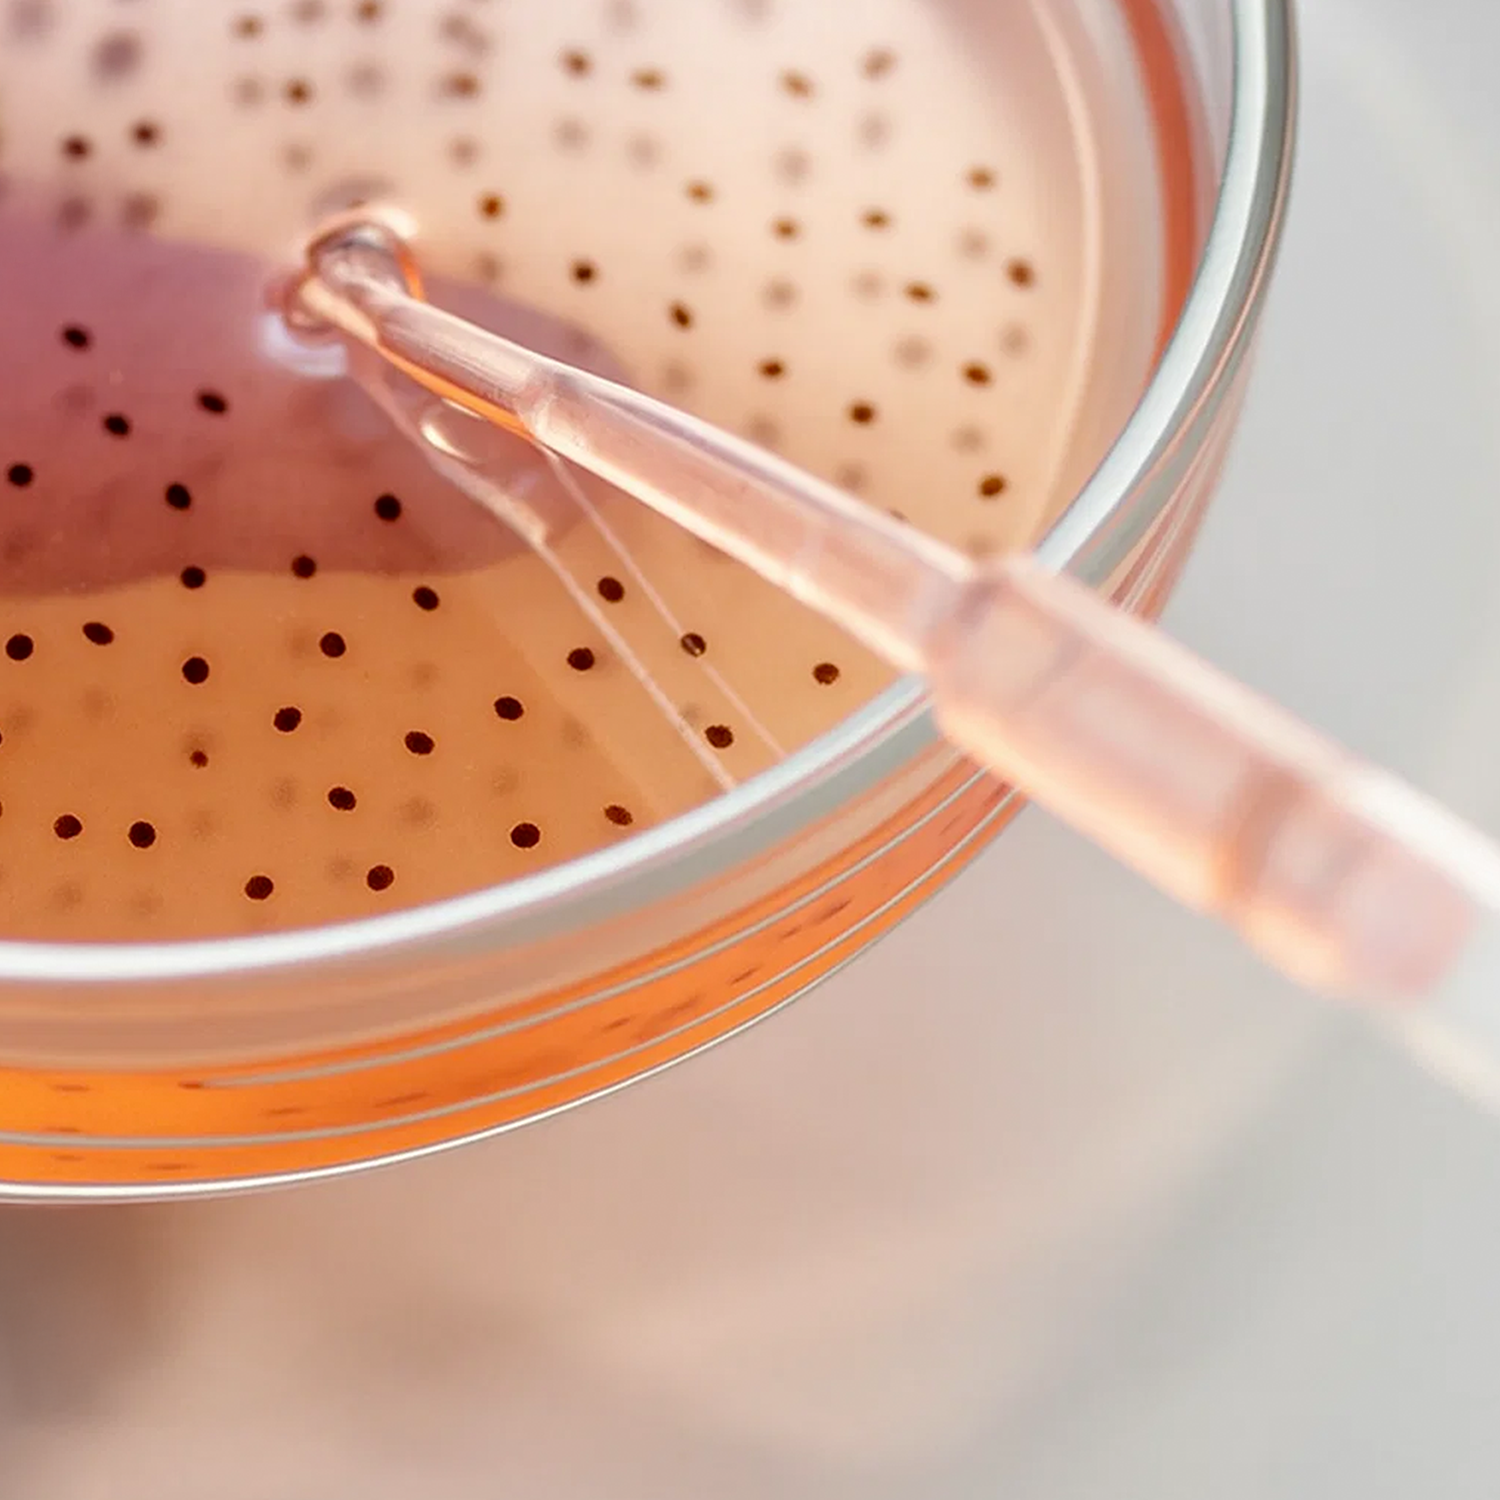

Das SPECIALIZED Prinzip
Source, Science & Safety
Unsere Basis für echte Gesundheit und deine Garantie genau das Richtige für deinen Körper zu tun.
SOURCE
Qualität vom Ursprung an
Qualität beginnt bei den Rohstoffen. SOURCE steht für transparente Herkunft, enge Partnerschaften mit den Erzeugern und den gezielten Einsatz von Markenrohstoffen mit belegter Wirkung. Hier fängt echte Qualität an – lange bevor das Produkt entsteht.
SCIENCE
Wirkstoffe auf Basis echter Forschung
Unsere Formulierungen folgen keinem Trend, sondern wissenschaftlicher Evidenz. SCIENCE sind intelligente Dosierungen, synergistische Kombinationen und bioaktive Verbindungen – entwickelt im eigenen NutriScience.LAB. So werden Zutaten zu wirksamen Lösungen.
SAFETY
Wirkung, die bleibt
Wirkstoffe sind sensibel. SAFETY garantiert, Frische und Wirksamkeit bis zur Einnahme. Durch Kleinchargen kontrollierte, kühle Lagerung und hochwertige Verpackungen, wie Pharma-Blister oder Braunglas, sichern wir die volle Wirkkraft – bis zur letzten Einnahme.
Transparenz, die überzeugt
Bei unseren Produkten findest Du Informationen zu Source, Science und Safety – damit Du genau weißt, wie wir Qualität, Forschung und Produktsicherheit leben.

Natürlich, durchdacht & für Menschen gemacht
Mit unserem SPECIALIZED Konzept sorgen wir dafür, dass Du genau die natürliche Lösung bekommst, die zu Deiner Gesundheit passt. Keine Standardrezepte, keine Überdosierungen – sondern individuelle Empfehlungen auf Basis neuester Wissenschaft, pharmazeutischer Sorgfalt und maximaler Transparenz.
Entwickelt von Experten
by Cellavent
NutriScience.LAB
Wenn du wissen möchtest wie unsere Produkte entwickelt werden dann schau gerne bei uns im Nutriscience.LAB vorbei
Mehr erfahren


![Zink Kapseln [Zink-Bisglycinat]](http://cellavent.de/cdn/shop/files/CH_essentials-zink-kapseln-Produktbilder_2025.png?v=1770314562&width=104)









